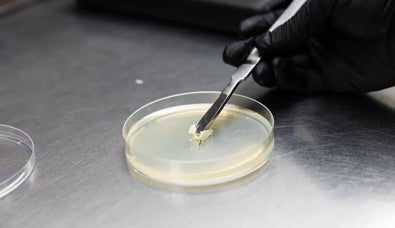
Lab Supplies

Trusted by 350k+ Growers
Free Shipping Over $199

Money Back Guarantee
Shop outdoor bestsellers
Not Sure Where to Start?
Tell us what you’re trying to grow (or ask anything), and we’ll recommend the best products for your setup, skill level, and environment.

What People Say
Loved by fungi fans of all kinds—from curious beginners to seasoned cultivators.
350,000+ happy customers
The Black Trumpet Blog

Why North Spore
Success Guaranteed
We guarantee free replacements for any damaged, contaminated, or unusable product.
Organic by Design
We use non-GMO raw materials to create our USDA certified organic products.
Expert Grow Support
Our team of mushroom experts and education library supports you at every step.
Trusted by Customers
Over 350,000 happy customers have experienced the magic of growing with North Spore.
Guides to growing mushrooms
Not to brag or anything, but North Spore is the #1 mushroom account on YouTube. Check us out!
MORE VIDEOS